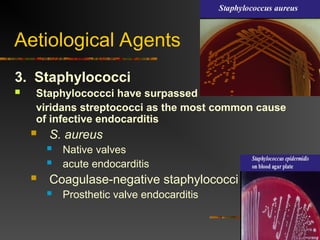
Aetiological Agents
3. Staphylococci
 Staphylococcci have surpassed
viridans streptococci as the most common cause
of infective endocarditis
 S. aureus
 Native valves
 acute endocarditis
 Coagulase-negative staphylococci
 Prosthetic valve endocarditis

The document provides a comprehensive overview of infections of the cardiovascular system, primarily focusing on infective endocarditis, its definition, pathogenesis, epidemiology, and diagnosis, along with complications and treatment options. It outlines the microbial agents responsible for endocarditis, their clinical manifestations, and diagnostic criteria established by the Duke criteria, while also addressing nosocomial infections and the role of prosthetic valves. The document emphasizes the importance of antimicrobial therapy and possible surgical interventions in managing these infections effectively.